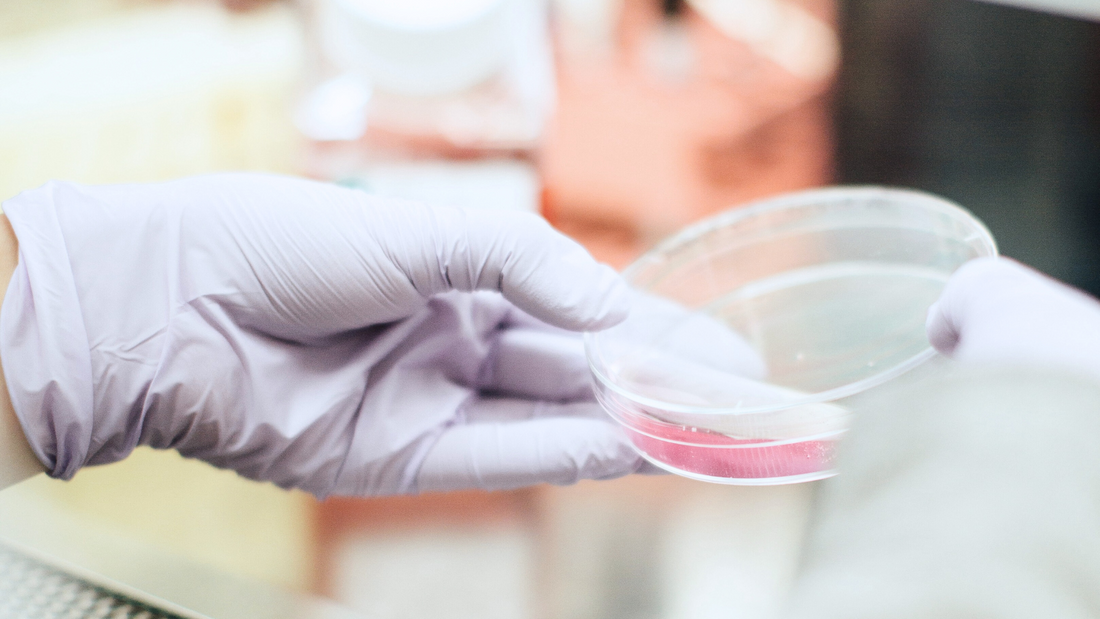

The idea that the gut microbiome affects mood via the gut-brain axis represents a paradigm shift in the field of mental health research. These studies suggest that our mental health is not all in our heads. In fact, our state of mind is intimately related to the communication that occurs between the gut and the brain. Further, our microbiome can impact it in more ways than you may have ever thought possible.
The Microbiome-Gut-Brain Axis and Mental Health
When you think about the last time you felt low or unable to focus, does the state of your gut come to mind? Many of us hold our brains responsible for our moods or mental state. Certain gut microbes, however, can play a role in influencing our mental health in a way you may have never considered - through an elegant system of pathways known as the gut-brain axis, or GBA.
This complex network links cognitive and emotional processes of the brain with the gut through bidirectional communication. Our brain function and gut are, in essence, in constant dialogue. And, the trillions of microbes that live in our gut may hold a significant amount of influence over our daily emotions and overall mental health via the GBA.
In this article, we will venture together on a fascinating journey of discovery into the intricate workings of this mind-body connection.
First, we will describe the different pathways through which the microbiome influences the brain via the GBA. Then, we will focus on how our gut bacteria can impact mental health outcomes. Finally, we will take a walk through time as we look at past and present research studies that reveal the extraordinary role that psychobiotics like PS128 can play in improving mood and mental well-being.
How the Gut-Brain Axis Impacts Mental Health
Embedded in the lining of the gut, 100s of millions of neurons are joined together in a mesh-like system that contains many of the same elements as the brain. This remarkable system contains its own reflexes and sensory capabilities which enable it to adapt to the distinct conditions of the gut in real-time – independent of input from the brain. So much so that our gut can conceivably still function without direction from the brain.
Nonetheless, our gut and brain rely on each other to maintain homeostasis (a state of balance) throughout the body using the bi-directional communication system known as the gut-brain axis (GBA). While incredibly complex, you can think of this system as a type of superhighway that connects our central nervous system (the brain and spinal cord) to our gut.
Through the gut-brain axis, the gut, including its own nervous system (enteric nervous system, or ENS) and microbiome, exert a profound influence on mood states and overall mental health.
The microbiome, in particular, is a key regulator of the gut-brain axis and key player in influencing mood states via various pathways that connect the gut to the brain.
This interconnection is also why taking certain probiotics called "psychobiotics" by mouth can affect brain function, and ultimately, our mental health. Extraordinary, right?
GBA Pathways: How the Microbiome Influences the Brain
Later in our journey, you will read about studies that describe the positive effects of psychobiotic administration on mood-related behaviors. Such a fascinating discovery may cause you to ask, how does the microbiome influence our mental states? The answer lies in the pathways that make up the gut-brain axis and input from our microbiome. Let’s dive in.
The microbiome potentially influences the brain via three major pathways of the gut-brain axis – vagus nerve (neurologic), circulatory, and immune:
Vagus Nerve Pathway: The vagus nerve directly interfaces with the microbiome and plays a central role in sending signaling messages between the microbiota and the brain. Microbes or microbial products can stimulate the vagus nerve to activate this pathway.
Circulatory Pathway: This pathway includes both metabolic and endocrine signals that can travel through the blood from the gut to the brain. For example, the microbiome influences the regulation of stress response pathways, including the metabolism of the stress hormone cortisol. Short-chain fatty acids (SCFA), products of the microbial breakdown of dietary fiber, may have a positive effect on mood and overall brain function.
Immune Pathway: The intestinal immune system senses and responds to gut microbes as well as microbial metabolites, releasing immune mediators that can indirectly impact behavior and mood. Many of these immune mediators also use the circulatory system to travel to the brain.
The gut uses chemical signals, such as neurotransmitters, immune mediators, and other chemical substances, to communicate with the brain via the gut-brain axis. Let’s take a closer look at one pathway in particular, the vagus nerve.
Spotlight: Serotonin, Vagus Nerve, and the Gut-Brain Axis
While multiple nerves connect the brain to the gut, the vagus nerve can be considered the most significant. The vagus nerve functions like a biological highway that links the brain and the gut, directly interfacing with the microbiome. The chemicals produced by the microbiome have the potential to indirectly (and possibly directly) influence the function of the central nervous system, but it is not entirely clear how. Some studies suggest that the microbiota may send signals to the brain by activating sensory neurons of the vagus nerve through both immune and endocrine pathways.
Consider serotonin. Also known as 5-HT, serotonin is widely recognized as a neurotransmitter that regulates mood. It is derived from the essential amino acid tryptophan (which must be obtained through food). About 5% of serotonin is produced from tryptophan in the brain, where it regulates mood, while the majority is made in the gut. However, gut-produced serotonin can’t reach the brain because of the blood-brain barrier.
Nevertheless, the gut may still influence the brain through the vagus nerve. The gut microbiota plays a part by regulating the metabolism of tryptophan that then is used by intestinal cells to produce serotonin. Beyond its essential roles in GI motility and development of the ENS, gut-produced serotonin also activates receptors on the vagus nerve that sends signals to the brain. These signals in turn may lead to changes in the brain that moderate mood, stress responses, and immune function.
In fact, studies suggest that a certain psychobiotic strain, PS128, can influence the levels of this feel-good neurotransmitter both in the brain and in the gut. Let’s take a closer look at research into the promising effects of psychobiotics on mental health.

Research Lens: Psychobiotics and Mental Health
Research has uncovered an extraordinary connection between the brain, the gut, and mental health. In essence, your gut’s microbiome may hold sway over how you feel. These studies have revealed that the gut’s microbiota influences several physiological processes, including those that impact mood and cognition.
Scientists have discovered that in some cases, certain probiotics seem to influence mental health. They are known as psychobiotics - probiotics that confer mental health benefits when administered in adequate quantities.
Through these studies, science has shown that specific probiotic strains may support mood and help us gain a more positive perspective on life.
Preclinical demonstrations of the gut-brain connection
Research, past and present, has demonstrated that the microbiome plays a pivotal role in regulating both brain function and behavior via the gut-brain axis. Rather recently, scientists have established that the brain and gut share a strong bi-directional relationship.
While most of this research is based on preclinical lab studies using animal models, some human observational studies have recently emerged. In these studies, scientists have observed that the gut microbiota may influence mental condition and behavior via neural pathways and associated feel-good neurotransmitters, serotonin and dopamine.
In 1998, microbiologist Mark Lyte discovered that the microbiome may exert a direct influence on mental health states. In this study, mice were given an oral administration of a bacterium known to cause food-borne infections, Camplyobacter jejuni. The mice were administered the bacteria in subclinical doses, which means the amount of pathogenic bacterium given did not result in immune activation of the host. The researchers observed anxiety-like behaviors in the test subjects following administration. The Lyte group confirmed this finding in a second more detailed research study.
These studies helped to confirm the link between the microbiome and mental health symptoms. In the decades since, the GBA and psychobiotics have become a focal point of mental health and neuroscience as scientists worldwide seek to uncover how the microbiome influences mood.
While the Lyte group established that “bad” bacteria can induce poor mental health, can certain strains of bacteria improve mental health symptoms?
The answer appears to be yes. In 2004, scientists in Japan reported that another specific bacterial species balanced stress hormone levels. Other research has focused on the effects of probiotic administration on low mood and stress-related behaviors to see if they improve mental health, including studies on PS128.
PS128 Studies and Mood
Psychological stress can take its toll on our mental health and may directly cause a reduction in serotonin and dopamine levels because of circulating stress hormones like cortisol. Psychobiotics may be able to reduce the impact of stress and increase good-feeling hormones like serotonin and dopamine.
For instance, a recent study observed the effects of the psychobiotic L. plantarum PS128 on stress and mental health in highly stressed information technology (IT) specialists. After an 8 week trial period, participants reported less self-perceived stress and improved overall well-being. Additionally, their salivary cortisol was reduced, which correlated with better mood and sleep.
While serotonin and dopamine are not easily measured in the brains of humans, preclinical studies can reveal the impact of psychobiotics on these important mood neurotransmitters. Several such studies of PS128 in animals revealed effects on serotonin and dopamine levels in particular parts of the brain. These changes correlated with some of the behaviors of the animals.
Specifically, in a preclinical model, PS128 was administered to germ-free mice to investigate the influence of the GBA on emotional behaviors. The animals were raised in a completely sterile environment and were devoid of any microorganisms in their gut, thus the term germ-free. Following administration of PS128, significantly increased locomotor activity and reduced anxiety-like behaviors of GF mice were recorded.
The authors of the study also noted increased levels of both serotonin and dopamine in the brain striatum (a deep region of the forebrain involved in action selection, control of movement, and motivation). These results indicate PS128’s potential to affect mental health independently of gut bacteria.
A different preclinical model where microbes were present showed that PS128 improved emotional well-being and behavior. Researchers from a (non-germ-free) preclinical model of early-life stress using PS128 reported a restoration of dopamine in a key area of the brain, and a reduction in the stress hormone cortisol.
The authors also noted an improvement in behaviors affected by stress. Lastly, a small randomized, placebo-controlled study in dogs, revealed that PS128 supplementation supported improved emotional status and behavior, based on reports from their owners.
These studies have demonstrated that the brain and gut are in constant communication. They also link administration of a specific probiotic strain, PS128, to a healthy stress response, mood, and mental health.
Psychobiotics Support Emotional Well-Being
The interconnectedness between each and every cell in our body is remarkable. This incredible connectivity is purely reflected in the complex communication system between our microbiome and the brain, the gut-brain axis. Here your brain and gut “talk” to each other through several pathways intricately woven together in a complex yet elegant system.
While most of us have experienced a time when anxious thoughts produced a reaction in our gut (like “butterflies in the stomach”), it’s important to keep in mind that the gut-brain connection is bi-directional. The contents of our guts can impact the mind and mental health, not just the other way around.
Recent research in both preclinical and clinical models has revealed that the gut microbiome plays an essential role in mental health through the gut-brain axis (GBA). This research has shown that the presence of pathogenic strains, even at subclinical levels, may contribute to mental health-related issues, including poor mood and increased anxiety-like symptoms.
Studies also have shown that the use of psychobiotics like PS128 can help support mood and overall emotional well-being. The ability to regulate brain neurotransmitters like dopamine and serotonin using a probiotic has the potential to improve mood in healthy people.
Recommended reading: